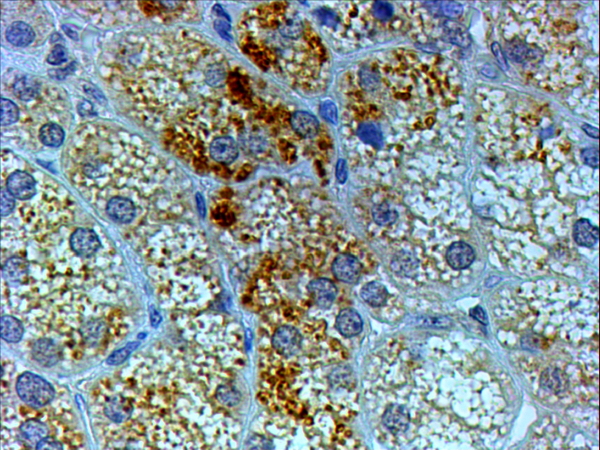

> Antigen, Antibodies, ELISA, Western Blot > Primary Antibody > Polyclonal Antibodies > Goat Anti-Proopiomelanocortin / POMC AntibodyBrand |
Leading Biology | Catalog Number |
AMM05098G |
Product Type |
Polyclonal Antibodies | Field of Research |
|
Product Overview |
We constantly strive to ensure we provide our customers with the best antibodies. As a result of this work we offer this antibody in purified format.
We are in the process of updating our datasheets. If you have any questions regarding this update, please feel free to contact our technical support team.
This product is a high quality Goat Anti-Proopiomelanocortin / POMC antibody.
|
||
Molecular Weight |
29424 Da
|
||
Cellular Localization |
Antigen Cellular Localization:
Secreted.
|
||
Host |
Goat
|
||
Species Reactivity |
Human, Mouse
|
||
Isotype |
IgG
|
||
GeneID |
|||
UniProt ID |
|||
Function |
ACTH stimulates the adrenal glands to release cortisol. Beta-endorphin and Met-enkephalin are endogenous opiates.
|
||
Summary |
This gene encodes a polypeptide hormone precursor that undergoes extensive, tissue-specific, post-translational processing via cleavage by subtilisin-like enzymes known as prohormone convertases. There are eight potential cleavage sites within the polypeptide precursor and, depending on tissue type and the available convertases, processing may yield as many as ten biologically active peptides involved in diverse cellular functions. The encoded protein is synthesized mainly in corticotroph cells of the anterior pituitary where four cleavage sites are used; adrenocorticotrophin, essential for normal steroidogenesis and the maintenance of normal adrenal weight, and lipotropin beta are the major end products. In other tissues, including the hypothalamus, placenta, and epithelium, all cleavage sites may be used, giving rise to peptides with roles in pain and energy homeostasis, melanocyte stimulation, and immune modulation. These include several distinct melanotropins, lipotropins, and endorphins that are contained within the adrenocorticotrophin and beta-lipotropin peptides. Mutations in this gene have been associated with early onset obesity, adrenal insufficiency, and red hair pigmentation. Alternatively spliced transcript variants encoding the same protein have been described.
|
||
Form |
0.5 mg IgG/ml in Tris saline (20mM Tris pH7.3, 150mM NaCl), 0.02% sodium azide, with 0.5% bovine serum albumin |
||
Storage & Stability |
Store at +4°C short term. For long-term storage, aliquot and store at -20°C or below. Stable for 12 months at -20°C. Avoid repeated freeze-thaw cycles.
|
||
Applications |
WB, IHC, E
|
||
Synonyms |
Pro-opiomelanocortin, POMC, Corticotropin-lipotropin, NPP, Melanotropin gamma, Gamma-MSH, Potential peptide, Corticotropin, Adrenocorticotropic hormone, ACTH, Melanotropin alpha, Alpha-MSH, Corticotropin-like intermediary peptide, CLIP, Lipotropin beta, Beta-LPH, Lipotropin gamma, Gamma-LPH, Melanotropin beta, Beta-MSH, Beta-endorphin, Met-enkephalin, POMC
|
||
Images |

AMM05098G (0.1 μg/ml) staining of lysates of cell line NIH3T3 (35 μg protein in RIPA buffer). Primary incubation was 1 hour. Detected by chemiluminescence.
AMM05098G (4 μg/ml) staining of paraffin embedded Human Adrenal Gland. Steamed antigen retrieval with citrate buffer pH 6, HRP-staining. |
||
Specification |
|||
Quantity |
|
||
| Select | Brand | Catalog No. | Product Name | Pack Size | Type | Field of Research | Specification | Quantity | Price(USD) | |
| 1 | Leading Biology | APR03440G | ITGA11 Antibody (N-term) | 100 μl | Polyclonal Antibodies |
|
$495.00 | Add Ask | ||
| 2 | Leading Biology | APR04537G | CMIP Antibody (C-term) | 100 μl | Polyclonal Antibodies |
|
$495.00 | Add Ask | ||
| 3 | Leading Biology | APR12422G | Human H4 Histamine Receptor (extracellular) Antibody | 50 μl | Polyclonal Antibodies |
|
$695.00 | Add Ask | ||
| 4 | Leading Biology | APR03844G | UBE2W Antibody (C-term) | 100 μl | Polyclonal Antibodies |
|
$495.00 | Add Ask | ||
| 5 | Leading Biology | APR04349G | HECTD2 Antibody (N-term) | 100 μl | Polyclonal Antibodies |
|
$495.00 | Add Ask | ||
| 6 | Leading Biology | APR03502G | IGHG1 Antibody (Center) | 100 μl | Polyclonal Antibodies |
|
$495.00 | Add Ask |
 Leading Biology Inc.
2600 Hilltop DR, Building G, B Suite C138
Richmond, CA, 94806
Tel: 1-661-524(LBI)-0262
Email: info@leadingbiology.com
Leading Biology Inc.
2600 Hilltop DR, Building G, B Suite C138
Richmond, CA, 94806
Tel: 1-661-524(LBI)-0262
Email: info@leadingbiology.com
Complete this form and click send to ask us a question, request a quote or simply say hello.

You have 0 item in your cart

You have 0 item in your inquiry list
